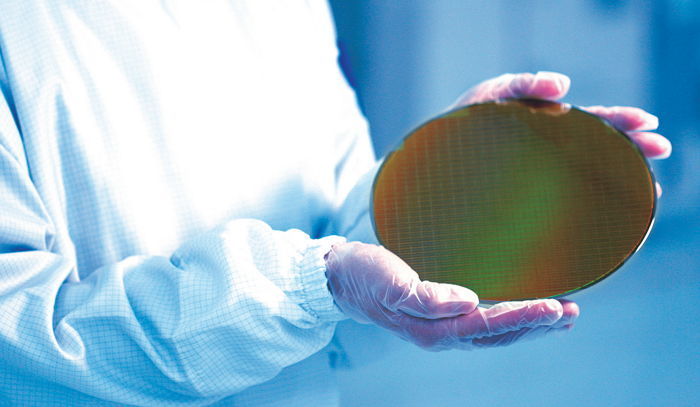
인사이트

기사와 관련 없는 사진 / 뉴스1
기사와 관련 없는 사진 / 뉴스1
[인사이트] 이경은 기자 = 중국의 IT회사들이 자사의 젊은 직원들을 우리나라 대학원생으로 위장 투입시켜 핵심 기술을 학습시키는 것으로 드러났다.
3일 아시아경제 보도에 따르면 첨단 산업 기업들의 연구·개발(R&D)센터가 밀집한 경기 판교 일대에 중국 IT 업체들의 사무실이 늘어나고 있다.
이들은 간판도 제대로 내걸지 않은 채 국내 사업을 위한 목적이 아닌 국내 대학에 자사의 직원들을 유학 보내기 위해 사무실을 내고 있는 것으로 전해졌다.
매체는 중국 IT 업체들의 목적은 기술 빼내기라고 전했다.
기사와 관련 없는 자료 사진 / gettyimagesBank
기사와 관련 없는 자료 사진 / gettyimagesBank
이 업체들은 국내 대기업과 산‧학‧연 과제를 진행하는 대학원에 자사의 젊은 직원들을 대학원생으로 위장 투입시켜 핵심 기술을 학습시킨 후 본사로 보내는 전력을 쓰고 있는 것으로 알려졌다.
국가정보원도 이를 산업스파이 활동의 일환으로 눈여겨보고 있지만 명확한 단서가 없어 손을 쓰지 못하는 상황인 것으로 전해졌다.
이에 정부는 주요 대학에 대한 핵심 기술 및 외국인 유학생 현황을 점검에 나섰다.
업계에 따르면 산업통상자원부는 최근 전국 주요 대학의 국가핵심기술 현황 및 해당 학과의 외국인 유학생에 대한 실태 조사를 진행 중이다.
정부는 이를 기반으로 연내 핵심기술 유출 방지를 위한 후속 조치를 마련하겠다는 계획이다.
 기사와 관련 없는 자료 사진 / gettyimagesBank
기사와 관련 없는 자료 사진 / gettyimagesBank
그렇다면 중국 IT업체들이 대학에 직원들을 보내는 이유는 무엇일까.
업계에서는 기업과 정부가 기술‧인재 유출 단속을 강화하자 상대적으로 보안이 허술한 대학을 매개로 기술유출을 시도하는 것으로 내다보고 있다.
그동안 중국 IT 업체들이 고액 연봉을 미끼로 삼성전자와 SK하이닉스 고위 기술 인력을 빼내간다는 사실이 여러 번 보도된 바 있다.
이에 산업부 측은 학교를 통해 중국 업체들이 핵심 기술을 빼 갈 가능성이 있다고 판단, 국내 대학에 대한 실태 조사를 진행하고 이를 근거로 지원에 나서겠다는 입장이다.